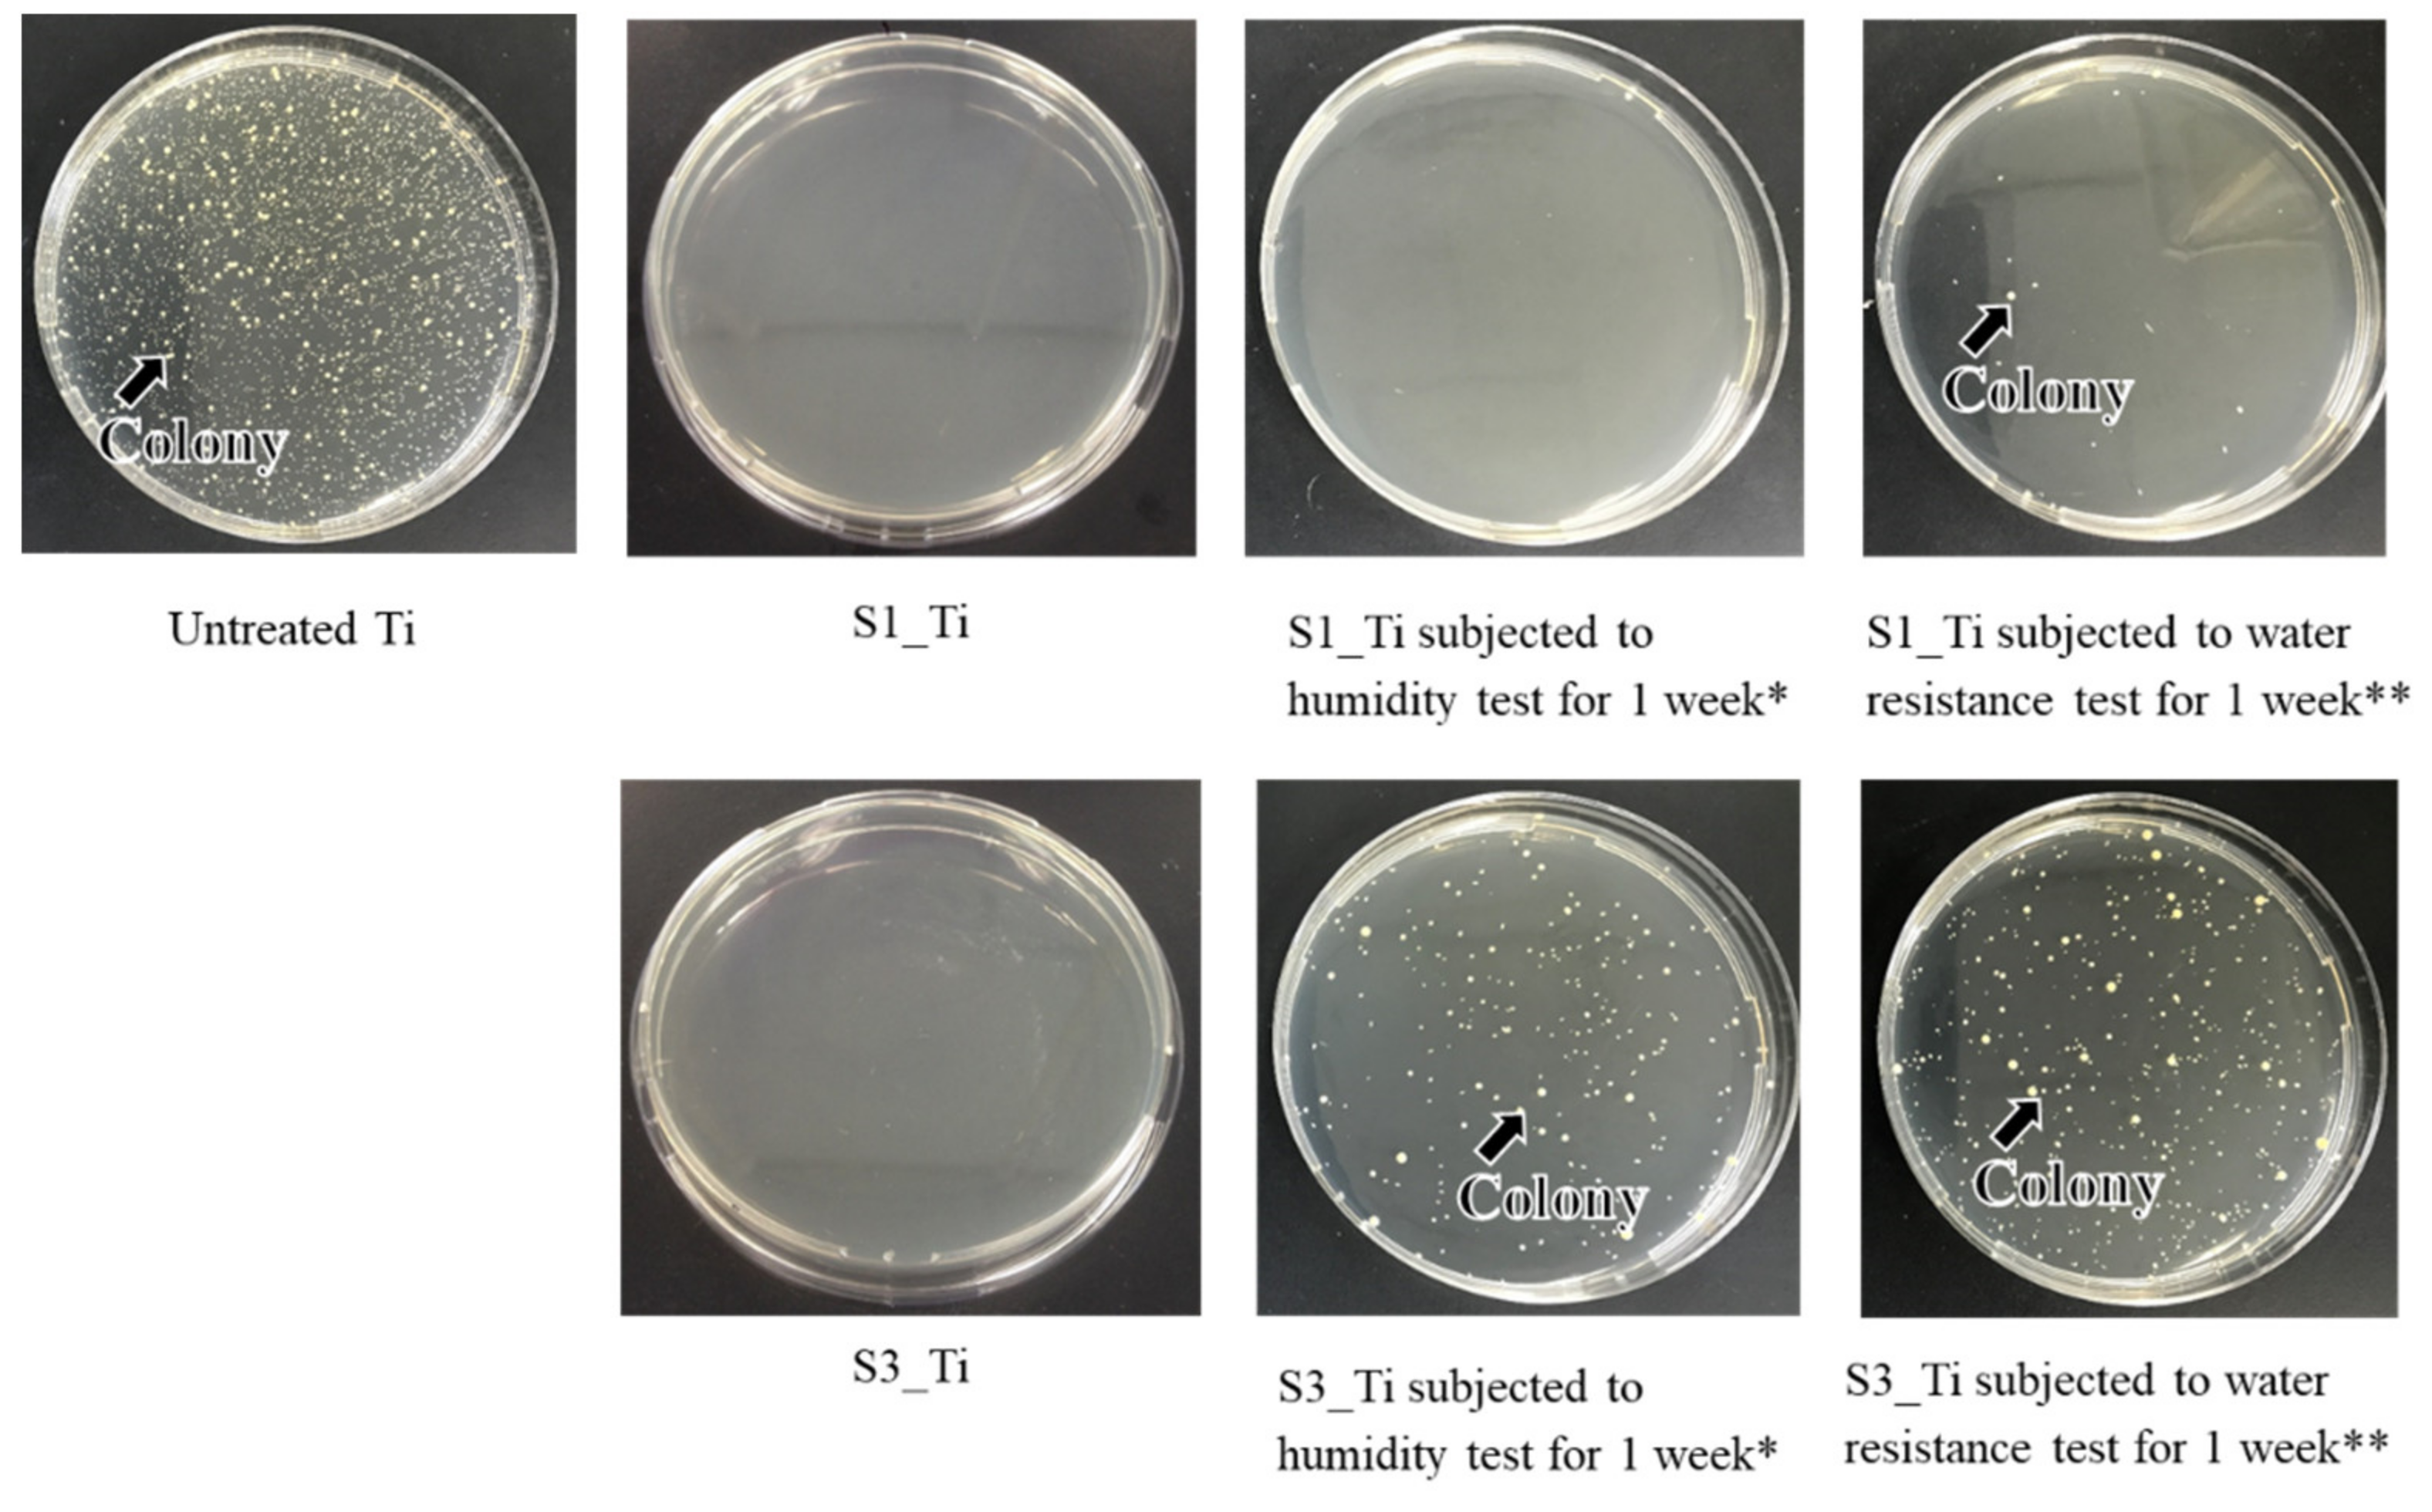
Nanomaterials 11 02199 g010 Nanomaterials 11 02199 g010

Iodine-Loaded Calcium Titanate for Bone Repair with Sustainable Antibacterial Activity Prepared by Solution and Heat Treatment
Abstract
1. Introduction
2. Materials and Methods
2.1. Materials Resources
2.2. Surface Treatment
2.3. Surface Characteristics
2.3.1. Scanning Electron Microscopy
2.3.2. X-ray Photoelectron Spectroscopy
2.3.3. Thin-Film X-ray Diffraction
2.3.4. Scratch Resistance Measurements
2.3.5. Zeta Potential Measurements
2.3.6. Ion Release
2.4. Apatite Formation
2.5. Cell Proliferation
2.6. Antibacterial Activity Test
2.7. Statistical Analysis
3. Results
3.1. The Surface Characteristics
3.2. Apatite Formation
3.3. Ion Release
3.4. Cell Proliferation
3.5. Antibacterial Activity
4. Discussion
5. Conclusions
- 1.
- High-capacity apatite formation: The treated metals have abundant acidic and basic Ti-OH groups and form apatite in SBF within 3 days;
- 2.
- Cytocompatibility: The Ti loaded with 8.6% iodine did not exhibit cytotoxicity to MC3T3-E1 or L929 cells;
- 3.
- Broad antibacterial spectrum: The Ti loaded with 8.6% iodine exhibited potent antibacterial activity (reduction rate > 99%) against not only MRSA but also S. aureus, E. coli, and S. epidermidis;
- 4.
- Sustainable antibacterial activity: The Ti loaded with 8.6% iodine exhibited a 97.3% reduction in MRSA even after being soaked in PBS under physiological conditions for 6 months.
Supplementary Materials
Author Contributions
Funding
Data Availability Statement
Acknowledgments
Conflicts of Interest
References
- Barfeie, A.; Wilson, J.; Rees, J. Implant surface characteristics and their effect on osseointegration. Br. Dent. J. 2015, 218, E9. [Google Scholar] [CrossRef] [PubMed]
- Yan, W.Q.; Nakamura, T.; Kobayashi, M.; Kim, H.M.; Miyaji, F.; Kokubo, T. Bonding of chemically treated titanium implants to bone. J. Biomed. Mater. Res. 1997, 37, 267–275. [Google Scholar] [CrossRef]
- Narayanan, R.; Seshadri, S.K.; Kwon, T.Y.; Kim, K.H. Calcium phosphate-based coatings on titanium and its alloys. J. Biomed. Mater. Res. Part B: Appl. Biomater. 2007, 85, 279–299. [Google Scholar] [CrossRef] [PubMed]
- Su, Y.; Cockerill, I.; Zheng, Y.; Tang, L.; Qin, Y.-X.; Zhu, D. Biofunctionalization of metallic implants by calcium phosphate coatings. Bioact. Mater. 2019, 4, 196–206. [Google Scholar] [CrossRef] [PubMed]
- Kokubo, T.; Yamaguchi, S. Novel bioactive materials developed by simulated body fluid evaluation: Surface-modified Ti metal and its alloys. Acta Biomater. 2016, 44, 16–30. [Google Scholar] [CrossRef] [PubMed]
- Le Guéhennec, L.; Soueidan, A.; Layrolle, P.; Amouriq, Y. Surface treatments of titanium dental implants for rapid osseointe-gration. Dent. Mater. 2007, 23, 844–854. [Google Scholar]
- Jemat, A.; Ghazali, M.J.; Razali, M.; Otsuka, Y. Surface Modifications and Their Effects on Titanium Dental Implants. BioMed Res. Int. 2015, 2015, 791725. [Google Scholar] [CrossRef]
- Park, J.-W.; Park, K.-B.; Suh, J.-Y. Effects of calcium ion incorporation on bone healing of Ti6Al4V alloy implants in rabbit tibiae. Biomaterials 2007, 28, 3306–3313. [Google Scholar] [CrossRef]
- Nayab, S.N.; Jones, F.H.; Olsen, I. Modulation of the human bone cell cycle by calcium ion-implantation of titanium. Biomaterials 2007, 28, 38–44. [Google Scholar] [CrossRef]
- Huang, Y.; Wang, W.; Zhang, X.; Liu, X.; Xu, Z.; Han, S.; Su, Z.; Liu, H.; Gao, Y.; Yang, H. A prospective material for orthopedic applications: Ti substrates coated with a composite coating of titania-nanotubes layer and a silver-manganese-doped hydroxyapatite layer. Ceram. Int. 2018, 44, 5528–5542. [Google Scholar] [CrossRef]
- Hacking, S.A.; Tanzer, M.; Harvey, E.; Krygier, J.J.; Bobyn, J.D. Relative Contributions of Chemistry and Topography to the Osseointegration of Hydroxyapatite Coatings. Clin. Orthop. Relat. Res. 2002, 405, 24–38. [Google Scholar] [CrossRef] [PubMed]
- Coelho, P.G.; Granjeiro, J.; Romanos, G.E.; Suzuki, M.; Silva, N.R.F.; Cardaropoli, G.; Thompson, V.P.; Lemons, J.E. Basic research methods and current trends of dental implant surfaces. J. Biomed. Mater. Res. Part B Appl. Biomater. 2009, 88, 579–596. [Google Scholar] [CrossRef]
- Souza, J.C.M.; Sordi, M.B.; Kanazawa, M.; Ravindran, S.; Henriques, B.; Silva, F.S.; Aparicio, C.; Cooper, L.F. Nano-scale modification of titanium implant surfaces to enhance osseointegration. Acta Biomater. 2019, 94, 112–131. [Google Scholar] [CrossRef] [PubMed]
- Yang, G.-L.; He, F.-M.; Yang, X.-F.; Wang, X.-X.; Zhao, S.-F. Bone responses to titanium implants surface-roughened by sandblasted and double etched treatments in a rabbit model. Oral Surg. Oral Med. Oral Pathol. Oral Radiol. Endodontol. 2008, 106, 516–524. [Google Scholar] [CrossRef] [PubMed]
- Kokubo, T.; Takadama, H. How useful is SBF in predicting in vivo bone bioactivity? Biomaterials 2006, 27, 2907–2915. [Google Scholar] [CrossRef] [PubMed]
- Zadpoor, A.A. Relationship between in vitro apatite-forming ability measured using simulated body fluid and in vivo bioac-tivity of materials. Mater. Sci. Eng. C Mater. Biol. Appl. 2014, 35, 134–143. [Google Scholar] [CrossRef]
- Karageorgiou, V.; Kaplan, D. Porosity of 3D biomaterial scaffolds and osteogenesis. Biomaterials 2005, 26, 5474–5491. [Google Scholar] [CrossRef]
- Taniguchi, N.; Fujibayashi, S.; Takemoto, M.; Sasaki, K.; Otsuki, B.; Nakamura, T.; Matsushita, T.; Kokubo, T.; Matsuda, S. Effect of pore size on bone ingrowth into porous titanium implants fabricated by additive manufacturing: An in vivo experiment. Mater. Sci. Eng. C Mater. Biol. Appl. 2016, 59, 690–701. [Google Scholar] [CrossRef]
- Wu, S.-H.; Li, Y.; Zhang, Y.-Q.; Li, X.-K.; Yuan, C.-F.; Hao, Y.-L.; Zhang, Z.-Y.; Guo, Z. Porous Titanium-6 Aluminum-4 Vanadium Cage Has Better Osseointegration and Less Micromotion Than a Poly-Ether-Ether-Ketone Cage in Sheep Vertebral Fusion. Artif. Organs 2013, 37, E191–E201. [Google Scholar] [CrossRef]
- Yang, J.; Cai, H.; Lv, J.; Zhang, K.; Leng, H.; Sun, C.; Wang, Z.; Liu, Z. In Vivo Study of a Self-Stabilizing Artificial Vertebral Body Fabricated by Electron Beam Melting. Spine 2014, 39, E486–E492. [Google Scholar] [CrossRef]
- Torres-Sanchez, C.; Al Mushref, F.; Norrito, M.; Yendall, K.; Liu, Y.; Conway, P. The effect of pore size and porosity on mechanical properties and biological response of porous titanium scaffolds. Mater. Sci. Eng. C 2017, 77, 219–228. [Google Scholar] [CrossRef] [PubMed]
- Bobbert, F.; Lietaert, K.; Eftekhari, A.A.; Pouran, B.; Ahmadi, S.; Weinans, H.; Zadpoor, A.A. Additively manufactured metallic porous biomaterials based on minimal surfaces: A unique combination of topological, mechanical, and mass transport properties. Acta Biomater. 2017, 53, 572–584. [Google Scholar] [CrossRef] [PubMed]
- Tilton, M.; Borjali, A.; Isaacson, A.; Varadarajan, K.M.; Manogharan, G.P. On structure and mechanics of biomimetic me-ta-biomaterials fabricated via metal additive manufacturing. Mater. Des. 2021, 201, 109498. [Google Scholar] [CrossRef]
- Kawai, T.; Takemoto, M.; Fujibayashi, S.; Akiyama, H.; Tanaka, M.; Yamaguchi, S.; Pattanayak, D.K.; Doi, K.; Matsushita, T.; Nakamura, T.; et al. Osteoinduction on Acid and Heat Treated Porous Ti Metal Samples in Canine Muscle. PLoS ONE 2014, 9, e88366. [Google Scholar] [CrossRef] [PubMed]
- Takemoto, M.; Fujibayashi, S.; Neo, M.; Suzuki, J.; Matsushita, T.; Kokubo, T.; Nakamura, T. Osteoinductive porous titanium implants: Effect of sodium removal by dilute HCl treatment. Biomaterials 2006, 27, 2682–2691. [Google Scholar] [CrossRef]
- Hamilton, H.; Jamieson, J. Deep infection in total hip arthroplasty. Can. J. Surg. 2008, 51, 111–117. [Google Scholar]
- Malawer, M.M.; Chou, L.B. Prosthetic survival and clinical results with use of large-segment replacements in the treatment of high-grade bone sarcomas. J. Bone Jt. Surg. Am. Vol. 1995, 77, 1154–1165. [Google Scholar] [CrossRef]
- Mahan, J.; Seligson, D.; Henry, S.L.; Hynes, P.; Dobbins, J. Factors in pin tract infections. Orthopedics 1991, 14, 305–308. [Google Scholar]
- O’Neill, E.; Awale, G.; Daneshmandi, L.; Umerah, O.; Lo, K.W.-H. The roles of ions on bone regeneration. Drug Discov. Today 2018, 23, 879–890. [Google Scholar] [CrossRef]
- Ferraris, S.; Venturello, A.; Miola, M.; Cochis, A.; Rimondini, L.; Spriano, S. Antibacterial and bioactive nanostructured tita-nium surfaces for bone integration. Appl. Surf. Sci. 2014, 311, 279–291. [Google Scholar] [CrossRef]
- Inoue, Y.; Uota, M.; Torikai, T.; Watari, T.; Noda, I.; Hotokebuchi, T.; Yada, M. Antibacterial properties of nanostructured silver titanate thin films formed on a titanium plate. J. Biomed. Mater. Res. Part A 2009, 92, 1171–1180. [Google Scholar] [CrossRef]
- Yamaguchi, S.; Le, P.T.M.; Ito, M.; Shintani, S.A.; Takadama, H. Tri-Functional Calcium-Deficient Calcium Titanate Coating on Titanium Metal by Chemical and Heat Treatment. Coatings 2019, 9, 561. [Google Scholar] [CrossRef]
- Okuzu, Y.; Fujibayashi, S.; Yamaguchi, S.; Masamoto, K.; Otsuki, B.; Goto, K.; Kawai, T.; Shimizu, T.; Morizane, K.; Kawata, T.; et al. In vitro study of antibacterial and osteogenic activity of titanium metal releasing strontium and silver ions. J. Biomater. Appl. 2021, 35, 670–680. [Google Scholar] [CrossRef]
- Masamoto, K.; Fujibayashi, S.; Yamaguchi, S.; Otsuki, B.; Okuzu, Y.; Kawata, T.; Goto, K.; Shimizu, T.; Shimizu, Y.; Kawai, T.; et al. Bioactivity and antibacterial activity of strontium and silver ion releasing titanium. J. Biomed. Mater. Res. Part B Appl. Biomater. 2020, 109, 238–245. [Google Scholar] [CrossRef]
- Spriano, S.; Yamaguchi, S.; Baino, F.; Ferraris, S. A critical review of multifunctional titanium surfaces: New frontiers for im-proving osseointegration and host response, avoiding bacteria contamination. Acta Biomater. 2018, 79, 1–22. [Google Scholar] [CrossRef]
- Fleischer, W.; Reiner, K. Povidone-iodine in antisepsis–state of the art. Dermatology 1997, 195, 3–9. [Google Scholar] [CrossRef] [PubMed]
- Solbak, M.S.; Henning, M.K.; England, A.; Martinsen, A.C.; Aaløkken, T.M.; Johansen, S. Impact of iodine concentration and scan parameters on image quality, contrast enhancement and radiation dose in thoracic CT. Eur. Radiol. Exp. 2020, 4, 1–8. [Google Scholar] [CrossRef]
- Takaya, M.; Hashimoto, K.; Maejima, M. Antimicrobial and Mold-Preventive Characteristics of Anodized Coating of Alu-minum Impregnated with Iodine Compound. J. Surf. Finish Soc. Jpn. 2000, 51, 324–327. [Google Scholar] [CrossRef]
- Tsuchiya, H.; Shirai, T.; Nishida, H.; Murakami, H.; Kabata, T.; Yamamoto, N.; Watanabe, K.; Nakase, J. Innovative antimicrobial coating of titanium implants with iodine. J. Orthop. Sci. 2012, 17, 595–604. [Google Scholar] [CrossRef]
- Shirai, T.; Shimizu, T.; Ohtani, K.; Zen, Y.; Takaya, M.; Tsuchiya, H. Antibacterial iodine-supported titanium implants. Acta Biomater. 2011, 7, 1928–1933. [Google Scholar] [CrossRef] [PubMed]
- Yavari, S.A.; Loozen, L.; Paganelli, F.L.; Bakhshandeh, S.; Lietaert, K.; Groot, J.A.; Fluit, A.C.; Boel, C.H.E.; Alblas, J.; Vogely, H.C.; et al. Antibacterial Behavior of Additively Manufactured Porous Titanium with Nanotubular Surfaces Releasing Silver Ions. ACS Appl. Mater. Interfaces 2016, 8, 17080–17089. [Google Scholar] [CrossRef] [PubMed]
- Kollath, V.O.; Chen, Q.; Mullens, S.; Luyten, J.; Traina, K.; Boccaccini, A.R.; Cloots, R. Electrophoretic deposition of hydrox-yapatite and hydroxyapatite-alginate on rapid prototyped 3D Ti6Al4V scaffolds. J. Mater. Sci. 2016, 51, 2338–2346. [Google Scholar] [CrossRef]
- Fukuda, A.; Takemoto, M.; Saito, T.; Fujibayashi, S.; Neo, M.; Yamaguchi, S.; Kizuki, T.; Matsushita, T.; Niinomi, M.; Kokubo, T.; et al. Bone bonding bioactivity of Ti metal and Ti–Zr–Nb–Ta alloys with Ca ions incorporated on their surfaces by simple chemical and heat treatments. Acta Biomater. 2010, 7, 1379–1386. [Google Scholar] [CrossRef] [PubMed]
- Yamaguchi, S.; Takadama, H.; Matsushita, T.; Nakamura, T.; Kokubo, T. Apatite-forming ability of Ti-15Zr-4Nb-4Ta alloy induced by calcium solution treatment. J. Mater. Sci. Mater. Med. 2010, 21, 439–444. [Google Scholar] [CrossRef]
- Luxbacher, T. The ZETA Guide Principles of the Streaming Potential Technique; Anton Paar: Graz, Austria, 2014. [Google Scholar]
- Yamaguchi, S.; Takadama, H.; Matsushita, T.; Nakamura, T.; Kokubo, T. Cross-sectional analysis of the surface ceramic layer de-veloped on Ti metal by NaOH-heat treatment and soaking in SBF. J. Ceram. Soc. Jpn. 2009, 117, 1126–1130. [Google Scholar] [CrossRef]
- Ferraris, S.; Cazzola, M.; Peretti, V.; Stella, B.; Spriano, S. Zeta Potential Measurements on Solid Surfaces for in Vitro Biomaterials Testing: Surface Charge, Reactivity Upon Contact with Fluids and Protein Absorption. Front. Bioeng. Biotechnol. 2018, 6, 60. [Google Scholar] [CrossRef]
- ISO22196:2011. Measurement of Antibacterial Activity on Plastics and Other Non-Porous Surfaces; ISO: Geneva, Switzerland, 2011. [Google Scholar]
- Ferraris, S.; Yamaguchi, S.; Barbani, N.; Cristallini, C.; di Confiengo, G.G.; Barberi, J.; Cazzola, M.; Miola, M.; Vernè, E.; Spriano, S. The mechanical and chemical stability of the interfaces in bioactive materials: The substrate-bioactive surface layer and hydroxyapatite-bioactive surface layer interfaces. Mater. Sci. Eng. C 2020, 116, 111238. [Google Scholar] [CrossRef]
- Schmitz, G. Inorganic reactions of iodine(+1) in acidic solutions. Int. J. Chem. Kinet. 2004, 36, 480–493. [Google Scholar] [CrossRef]
- Liu, H.; Cui, X.; Lu, X.; Liu, X.; Zhang, L.; Chan, T.-S. Mechanism of Mn incorporation into hydroxyapatite: Insights from SR-XRD, Raman, XAS, and DFT calculation. Chem. Geol. 2021, 579, 120354. [Google Scholar] [CrossRef]
- Kokubo, T.; Yamaguchi, S. Novel Bioactive Titanate Layers Formed on Ti Metal and Its Alloys by Chemical Treatments. Materials 2009, 3, 48–63. [Google Scholar] [CrossRef]
- Fujibayashi, S.; Neo, M.; Kim, H.-M.; Kokubo, T.; Nakamura, T. A comparative study between in vivo bone ingrowth and in vitro apatite formation on Na2O–CaO–SiO2 glasses. Biomaterials 2003, 24, 1349–1356. [Google Scholar] [CrossRef]
- Okuzu, Y.; Fujibayashi, S.; Yamaguchi, S.; Yamamoto, K.; Sono, T.; Goto, K.; Otsuki, B.; Matushita, T.; Kokubo, T.; Matsuda, S. Strontium and magnesium ions released from bioactive titanium metal promote early bone bonding in a rabbit implant model. Acta Biomater. 2017, 63, 383–392. [Google Scholar] [CrossRef]
- Ferraris, S.; Yamaguchi, S.; Barbani, N.; Cazzola, M.; Cristallini, C.; Miola, M.; Vernè, E.; Spriano, S. Bioactive materials: In vitro investigation of different mechanisms of hydroxyapatite precipitation. Acta Biomater. 2019, 102, 468–480. [Google Scholar] [CrossRef] [PubMed]
- Adachi, M.; Eguchi, W.; Tohdo, F.; Yoneda, M. Reactions of iodine in aqueous solutions containing sodium hydroxide. J. Chem. Eng. Jpn. 1974, 7, 360–363. [Google Scholar] [CrossRef][Green Version]
- Baino, F.; Yamaguchi, S. The Use of Simulated Body Fluid (SBF) for Assessing Materials Bioactivity in the Context of Tissue Engineering: Review and Challenges. Biomimetics 2020, 5, 57. [Google Scholar] [CrossRef] [PubMed]
- Tsukanaka, M.; Yamamoto, K.; Fujibayashi, S.; Pattanayak, D.K.; Matsushita, T.; Kokubo, T.; Matsuda, S.; Akiyama, H. Evaluation of bioactivity of alkali- and heat-treated titanium using fluorescent mouse osteoblasts. J. Bone Miner. Metab. 2013, 32, 660–670. [Google Scholar] [CrossRef]
- Liu, J.X.; Werner, J.A.; Buza, J.A., III; Kirsch, T.; Zuckerman, J.D.; Virk, M.S. Povidone-iodine Solutions Inhibit Cell Migration and Survival of Osteoblasts, Fibroblasts, and Myoblasts. Spine 2017, 42, 1757–1762. [Google Scholar] [CrossRef] [PubMed]
- Brown, R.F.; Rahaman, M.N.; Dwilewicz, A.B.; Huang, W.; Day, D.E.; Li, Y.; Bal, B.S. Effect of borate glass composition on its conversion to hydroxyapatite and on the proliferation of MC3T3-E1 cells. J. Biomed. Mater. Res. Part A 2008, 88A, 392–400. [Google Scholar] [CrossRef]
- Rahman, M.N.; Day, D.E.; Bal, B.S.; Fu, Q.; Jung, S.B.; Bonewald, L.F.; Tomsia, A.P. Bioactive glass in tissue engineering. Acta Biomater. 2011, 7, 2355–2373. [Google Scholar] [CrossRef]
- Matsushita, K.; Abe, S.; Ishi, T.; Kajiyama, S.; Kotani, A.; Saito, M.; Masaoka, N.; Suguro, T. Prevention of perioperative infection in bone and joints. Jpn. J. Chemother. 2012, 60, 319–326. [Google Scholar]

| Sample | Substrate | NaOH-CaCl2-Heat Treatment | Iodine Treatment |
|---|---|---|---|
| Untreated Ti | Ti | Not treated | Not treated |
| C_Ti | Ti | Treated | Not treated |
| S1_Ti | Ti | Treated | 10 mM ICl3, 80 °C |
| S2_Ti | Ti | Treated | 100 mM ICl3, 80 °C |
| S3_Ti | Ti | Treated | 100 mM ICl3, 60 °C |
| S4_Ti | Ti | Treated | 100 mM ICl3, 40 °C |
| S5_Ti | Ti | Treated | 10% ICl, 60 °C |
| S1_Ti64 | Ti-6Al-4V | Treated | 100 mM ICl3, 80 °C |
| S1_Ti1544 | Ti-15Zr-4Nb-4Ta | Treated | 100 mM ICl3, 80 °C |
| S6_Ti | Ti | Treated | 1000 ppm Polyvinylpyrrolidone, 60 °C |
| S7_Ti | Ti | Treated | 100 mM NaI, 60 °C |
| Element/Mass% | |||||||||
|---|---|---|---|---|---|---|---|---|---|
| Sample | O | Ti | Al | V | Zr | Nb | Ta | Ca | I |
| Untreated Ti | 48.6 | 51.4 | - | - | - | - | - | 0.0 | 0.0 |
| C_Ti | 43.2 | 48.5 | - | - | - | - | - | 8.3 | 0.0 |
| S1_Ti | 42.7 | 46.1 | - | - | - | - | - | 2.6 | 8.6 |
| S2_Ti | 41.2 | 55.4 | - | - | - | - | - | 1.4 | 1.9 |
| S3_Ti | 39.0 | 52.4 | - | - | - | - | - | 6.2 | 2.3 |
| S4_Ti | 39.7 | 52.1 | - | - | - | - | - | 7.5 | 0.7 |
| S5_Ti | 44.2 | 50.5 | - | - | - | - | - | 2.3 | 3.1 |
| S1_Ti64 | 40.0 | 46.3 | 0 | 0 | - | - | - | 3.2 | 10.5 |
| S1_Ti1544 | 37.1 | 39.3 | - | - | 3.0 | 1.9 | 7.3 | 4.0 | 7.3 |
| S6_Ti | 48.0 | 45.4 | - | - | - | - | - | 6.6 | 0.0 |
| S7_Ti | 43.1 | 50.2 | - | - | - | - | - | 6.8 | 0.0 |
| Sample | Critical Scratch Load (mN) | Statistically Significant Difference |
|---|---|---|
| C_Ti | 31.8 ± 2.0 | † |
| S1_Ti | 33.3 ± 8.8 | † |
| S2_Ti | 27.6 ± 2.9 | †,* |
| S3_Ti | 25.3 ± 5.0 | †,* |
| S4_Ti | 26.5 ± 2.5 | †,* |
| S5_Ti | 26.4 ± 2.8 | †,* |
| S1_Ti64 | 41.5 ± 4.2 | † |
| S1_Ti1544 | 119.0 ± 9.9 |
| Sample | Ca (Mass%) | I (Mass%) | Crystallin Phase * | Critical Scratch Load (mN) | Apatite Formation (Soaked in SBF for 3 d) |
|---|---|---|---|---|---|
| C_Ti | 8.3 | 0.0 | CT, R | 33.3 ± 2.0 | × |
| S1_Ti | 2.6 | 8.6 | ICT, R | 33.3 ± 8.8 | ○ |
| S2_Ti | 1.4 | 1.9 | ICT, R | 27.6 ± 2.9 | ○ |
| S3_Ti | 6.2 | 2.3 | ICT, R | 25.3 ± 5.0 | ○ |
| S4_Ti | 7.5 | 0.7 | ICT, R | 26.5 ± 2.5 | ○ |
| S5_Ti | 2.3 | 3.1 | ICT, R | 26.4 ± 2.8 | ○ |
| S1_Ti64 | 3.2 | 10.5 | ICT, R | 41.5 ± 4.2 | ○ |
| S1_Ti1544 | 4.0 | 7.3 | ICT, R | 119.0 ± 9.9 | ○ |
| S6_Ti | 6.6 | 0.0 | ** | - | - |
| S7_Ti | 6.8 | 0.0 | - | - | - |
| Average of MRSA Count/CFU | Average of S. aureus Count/CFU | |||||
|---|---|---|---|---|---|---|
| Sample | After Inoculation | After Incubation | A Value * | After Inoculation | After Incubation | A Value |
| Untreated Ti | 2.3 × 106 | 4.4 × 105 | - | 1.2 × 107 | 6.0 × 106 | - |
| S1_Ti | 1.3 × 106 | <20 | 4.3 | 1.1 × 107 | <20 | 5.5 |
| S1_Ti + MR ** (1 week) | 8.0 × 105 | <20 | 4.3 | 1.0 × 107 | 1.2 × 103 | 3.7 |
| S1_Ti + WR *** (1 week) | 1.9 × 106 | 2.2 × 103 | 2.3 | 1.2 × 107 | 1.3 × 105 | 1.7 |
| Average of E. coli Count/CFU | Average of S. epidermidis Count/CFU | |||||
|---|---|---|---|---|---|---|
| Sample | After Inoculation | After Incubation | A Value * | After Inoculation | After Incubation | A Value |
| Untreated | 1.6 × 105 | 1.7 × 106 | - | 4.0 × 10⁴ | 8.5 × 10⁴ | - |
| S1_Ti | 1.2 × 105 | <20 | 4.9 | 4.1 × 10⁴ | <20 | 3.6 |
| S1_Ti + MR ** (1 week) | 1.2 × 105 | <20 | 4.9 | |||
| S1_Ti + WR *** (1 week) | 8.8 × 104 | 9.2 × 103 | 2.3 | |||
Publisher’s Note: MDPI stays neutral with regard to jurisdictional claims in published maps and institutional affiliations. |
© 2021 by the authors. Licensee MDPI, Basel, Switzerland. This article is an open access article distributed under the terms and conditions of the Creative Commons Attribution (CC BY) license (https://creativecommons.org/licenses/by/4.0/).
Share and Cite
Yamaguchi, S.; Le, P.T.M.; Shintani, S.A.; Takadama, H.; Ito, M.; Ferraris, S.; Spriano, S. Iodine-Loaded Calcium Titanate for Bone Repair with Sustainable Antibacterial Activity Prepared by Solution and Heat Treatment. Nanomaterials 2021, 11, 2199. https://doi.org/10.3390/nano11092199
Yamaguchi S, Le PTM, Shintani SA, Takadama H, Ito M, Ferraris S, Spriano S. Iodine-Loaded Calcium Titanate for Bone Repair with Sustainable Antibacterial Activity Prepared by Solution and Heat Treatment. Nanomaterials. 2021; 11(9):2199. https://doi.org/10.3390/nano11092199
Chicago/Turabian StyleYamaguchi, Seiji, Phuc Thi Minh Le, Seine A. Shintani, Hiroaki Takadama, Morihiro Ito, Sara Ferraris, and Silvia Spriano. 2021. "Iodine-Loaded Calcium Titanate for Bone Repair with Sustainable Antibacterial Activity Prepared by Solution and Heat Treatment" Nanomaterials 11, no. 9: 2199. https://doi.org/10.3390/nano11092199
APA StyleYamaguchi, S., Le, P. T. M., Shintani, S. A., Takadama, H., Ito, M., Ferraris, S., & Spriano, S. (2021). Iodine-Loaded Calcium Titanate for Bone Repair with Sustainable Antibacterial Activity Prepared by Solution and Heat Treatment. Nanomaterials, 11(9), 2199. https://doi.org/10.3390/nano11092199

